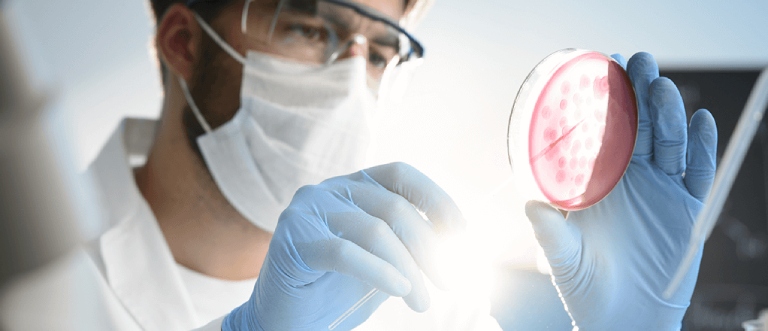

Trầm cảm ở người cao tuổi vì sao ngày càng phổ biến?
Khi trải qua hàng loạt thăng trầm trong cuộc đời, khi tuổi cao sức yếu, người già thường cảm thấy buồn bã, chán nản, tuyệt vọng không rõ nguyên nhân. Theo thống kê, ít nhất 1 trong 6 người cao tuổi mắc phải căn bệnh trầm cảm. Vậy vì sao trầm cảm ở người cao tuổi ngày càng phổ biến? Bệnh biểu hiện như thế nào? Phương pháp điều trị ra sao?

Thực trạng bệnh trầm cảm ở người cao tuổi
Đối với người già, trầm cảm thường xuất hiện cùng lúc với những bệnh lý khác và có xu hướng phát triển mạn tính. Bệnh trầm cảm ở người già có thể làm giảm khả năng phục hồi tự nhiên của cơ thể và gia tăng nguy cơ bị bệnh tim mạch hoặc tử vong do bệnh tật. Đặc biệt, tình trạng này cũng làm tăng nguy cơ tự tử ở người cao tuổi, nhất là người cao tuổi da trắng.
Tỷ lệ tự tử vì trầm cảm ở những người trong độ tuổi 80 – 84 cao gấp đôi so với dân số nói chung. Khoảng 15% người già có biểu hiện trầm cảm. Tỷ lệ tái phát trầm cảm ở người cao tuổi rất cao. Viện Sức khỏe Tâm thần Quốc gia Hoa Kỳ nhận định, bệnh trầm cảm ở đối tượng từ 65 tuổi trở lên là một trong những vấn đề sức khỏe cộng đồng nan giải.
Chúng ta cần quan tâm đặc biệt đến sức khỏe người cao tuổi bởi hệ miễn dịch và sức đề kháng của họ đang suy giảm nhanh chóng. Tuy nhiên, trong quá trình thăm khám, bác sĩ thường bỏ qua những dấu hiệu nhận biết của bệnh trầm cảm. Điều này khiến các triệu chứng càng thêm tồi tệ, đồng thời làm tăng mức độ nghiêm trọng của những căn bệnh khác.
Hiện nay, định kiến của cộng đồng, xã hội dành cho những bệnh nhân lớn tuổi đang điều trị các dạng rối loạn tâm thần vẫn còn rất khắt khe và nặng nề. Trước sự kỳ thị này, người già cố tình phớt lờ, che giấu và không muốn thăm khám, chữa bệnh.
Các sự kiện bất hạnh trong cuộc sống như: bị cô lập, bỏ bê, sống trong cảnh nghèo khổ, đói kém, chứng kiến cái chết của bạn bè, người thân… sẽ tác động sâu sắc đến trạng thái tâm lý và động lực điều trị của bệnh nhân.
Thêm vào đó, thói quen nghiện thuốc lá, rượu bia và các chất kích thích sẽ góp phần cản trở quá trình chữa bệnh. Ngoài ra, các vấn đề sức khỏe khác, chi phí cần thiết và tác dụng không mong muốn của thuốc chống trầm cảm là những yếu tố ảnh hưởng lớn đến công tác điều trị.
Bệnh trầm cảm khiến người bệnh luôn chỉ trích, trừng phạt, đổ lỗi cho bản thân về tất cả những sự việc không như ý xảy ra trong cuộc sống cá nhân. Khi mắc phải tình trạng này, người già sẽ chìm đắm trong nhiều suy nghĩ bi quan, tiêu cực và trở nên u sầu, buồn bã, chán nản, bế tắc. Chính những điều này khiến cho bệnh trầm cảm ở người cao tuổi ngày càng phổ biến hơn bao giờ hết.
Nguyên nhân gây trầm cảm ở người cao tuổi
Nguyên nhân của bệnh trầm cảm ở người già có thể xuất phát từ:
- Ám ảnh về những trải nghiệm đau buồn trong quá khứ (nhất là sự ra đi của những người thân thương)
- Gặp phải khó khăn quá lớn (thất nghiệp, nghèo khó, bị phản bội, bị ruồng bỏ, trục trặc trong hôn nhân, gia đình…)
- Đau ốm triền miên
- Sử dụng một số loại thuốc có thể dẫn đến triệu chứng trầm cảm
Những yếu tố làm tăng nguy cơ mắc bệnh trầm cảm ở người cao tuổi bao gồm:
- Giới tính nữ
- Độc thân, sống một mình, chưa lập gia đình, ly hôn hoặc góa chồng/vợ
- Cuộc sống thiếu thốn, căng thẳng
- Không nhận được sự quan tâm đúng mức từ gia đình, xã hội
- Bị tiểu đường, tăng huyết áp, ung thư, mất trí, rung tâm nhĩ, đau mạn tính, đột quỵ
- Có người thân mắc bệnh trầm cảm
- Bị chấn thương cơ thể: phẫu thuật, cắt cụt…
- Từng bị trầm cảm trước đây
- Lạm dụng hóa chất và chất kích thích
Triệu chứng bệnh trầm cảm ở người già
Thông thường, các triệu chứng lâm sàng của bệnh trầm cảm ở người cao tuổi kéo dài tối thiểu 2 tuần. Trong khoảng thời gian này, tâm trạng của bệnh nhân sẽ bị ảnh hưởng nghiêm trọng. Vì vậy, năng suất lao động cũng giảm đi đáng kể. Những biểu hiện của căn bệnh này bao gồm:
- Không còn hứng thú, say mê với những sở thích trước đây
- Không muốn làm bất kỳ điều gì, mệt mỏi không rõ lý do
- Chán ăn, mất cảm giác ngon miệng, sút cân theo thời gian
- Cảm thấy khó chịu, lo lắng bất thường
- Hạn chế gặp gỡ, giao lưu, cố tình tránh mặt mọi người
- Trở nên nhạy cảm và hay cáu gắt vô cớ
- Khó ngủ, thiếu ngủ, mất ngủ, hay giật mình, khó ngủ tiếp, dậy sớm hơn 1 – 2 tiếng so với bình thường
- Tự ti, sợ hãi, cảm giác tội lỗi, tồi tệ, hoảng sợ, vô giá trị
- Nảy sinh ý định tự sát

Nhìn chung, các triệu chứng của bệnh trầm cảm ở người cao tuổi khó chẩn đoán và rất dễ bị nhầm lẫn với biểu hiện của nhiều bệnh lý khác.
Bác sĩ chuyên khoa sẽ đưa ra hàng loạt câu hỏi gắn liền với những tiêu chuẩn chẩn đoán nhất định nhằm đánh giá chính xác và đề ra phương hướng chữa trị an toàn, phù hợp nhất với từng bệnh nhân. Các chuyên gia khuyến cáo, người già nên thường xuyên thăm khám sàng lọc trầm cảm để chủ động bảo vệ sức khỏe tinh thần của bản thân.
Hậu quả của bệnh trầm cảm ở người cao tuổi
Bệnh trầm cảm ở người cao tuổi khiến người bệnh mất đi cảm giác ngon miệng, chán ăn, sụt cân, thiếu hụt dưỡng chất. Bên cạnh đó, vì bị rối loạn giấc ngủ triền miên, bệnh nhân dần dần ốm yếu, mệt mỏi, uể oải và dễ bị các vấn đề về tâm thần, thần kinh.
Cảm giác thất vọng, buồn bã, chán nản cùng hàng loạt suy nghĩ tiêu cực tạo nên nhiều áp lực vô hình trong tâm trí. Điều này làm người bệnh lo nghĩ thái quá và thường mắc bệnh tim mạch.
Ngoài ra, bệnh lý cũng ảnh hưởng lớn đến trí nhớ của người già. Thậm chí, một số bệnh nhân còn nghi ngờ bản thân bị mất trí vì đã lớn tuổi. Trên thực tế, tình trạng bất an, lo âu, phiền muộn lâu ngày khiến người bệnh ám ảnh quá khứ và suy giảm trí nhớ, sa sút trí tuệ.
Phương pháp điều trị bệnh trầm cảm ở người cao tuổi
Trong quá trình chữa bệnh, hai phương pháp điều trị nội khoa và trị liệu tâm lý có thể mang đến hiệu quả tốt như nhau. Bác sĩ chuyên khoa thường chỉ định sử dụng thuốc chống trầm cảm nếu các triệu chứng trở nên nghiêm trọng hoặc bệnh tình tiếp diễn trong một khoảng thời gian dài.
Thuốc chống trầm cảm thường phát huy hiệu quả nhanh chóng hơn so với kỹ thuật trị liệu tâm lý. Để rút ngắn thời gian điều trị, bệnh nhân có thể kết hợp cả hai phương pháp này dưới sự giám sát chặt chẽ của chuyên gia. Nhìn chung, bệnh trầm cảm ở người cao tuổi sẽ phục hồi chỉ sau vài tuần, vài tháng, thậm chí một hay hai năm sau khi tiến hành chữa bệnh.
1. Dùng thuốc chống trầm cảm
Nếu người bệnh khó ngủ, chán ăn/ăn nhiều, tăng cân/giảm cân hoặc mắc bệnh lâu ngày, bác sĩ chuyên khoa sẽ yêu cầu họ sử dụng một hoặc một số loại thuốc chống trầm cảm. Khoảng 50 – 60% ca bệnh đáp ứng tốt với thuốc điều trị.
Hiện nay, trên thị trường có nhiều loại thuốc chống trầm cảm khác nhau. Việc lựa chọn loại thuốc trầm cảm an toàn, phù hợp với người già tương đối phức tạp bởi nhóm đối tượng này cũng đang gặp phải nhiều bệnh lý khác. Do đó, bác sĩ cần cân nhắc kỹ lưỡng về vấn đề tác dụng phụ và tương tác thuốc.
Người bệnh hãy thông báo cho bác sĩ biết về tất cả loại thuốc bản thân đang sử dụng (bao gồm thảo mộc, thuốc bổ, vitamin, thuốc không bán theo toa). Điều quan trọng nhất là mọi loại thuốc chống trầm cảm sẽ phát huy công dụng tối đa trong 4 – 6 tuần. Vì vậy, độc giả hãy cố gắng tuân thủ phác đồ điều trị.
Trong công tác chữa bệnh, các loại thuốc chống trầm cảm phổ biến nhất thường là những chất ức chế tái hấp thu serotonin chọn lọc, gồm có: celexa (citalopram), paxil (paroxetine), zoloft (sertraline), prozac (fluoxetine)…
Là loại thuốc chống trầm cảm mới nhất, celexa thường ít tương tác hơn so với những loại thuốc khác. Các tác dụng không mong muốn thường gặp của nhóm thuốc tái hấp thu serotonin là: mất ngủ, bồn chồn, rối loạn chức năng tình dục. Để giảm thiểu tình trạng này, các bác sĩ chuyên khoa sẽ chỉ định bệnh nhân dùng thuốc liều thấp lúc đầu, sau đó tăng dần liều lượng.
2. Trị liệu tâm lý
Trị liệu tâm lý là một trong những phương pháp điều trị trầm cảm quan trọng. Các chuyên gia tâm lý được đào tạo bài bản để kiên nhẫn lắng nghe, cung cấp kiến thức và hỗ trợ bệnh nhân nhìn nhận cuộc sống một cách đúng đắn, tích cực hơn.
Kỹ thuật này giúp độc giả nhận thấy tư duy, suy nghĩ tiêu cực, bi quan khiến bản thân trầm cảm, từ đó điều chỉnh nhận thức và hành vi theo hướng thực tế, lạc quan. Ngoài ra, gia đình nên thường xuyên trò chuyện, chia sẻ và quan tâm chăm sóc người bệnh. Giải pháp đơn giản này có thể giúp họ nhanh chóng vượt qua căn bệnh trầm cảm.
3. Liệu pháp sốc điện Electroconvulsive (ECT)
Liệu pháp sốc điện (Electroconvulsive – ECT) có thể cải thiện triệu chứng trầm cảm ở người cao tuổi một cách hiệu quả. Khi bệnh nhân không thể dùng thuốc chống trầm cảm vì tương tác thuốc, gặp phải tác dụng không mong muốn hoặc nảy sinh ý định tự tử, bác sĩ chuyên khoa sẽ chỉ định phương pháp điều trị an toàn này.
4. Sử dụng thực phẩm phẩm chức năng
- Thực phẩm chức năng từ thảo dược St. John’s Wort
Người bệnh có thể tìm mua những loại thực phẩm chức năng được chiết xuất từ thảo dược St. John’s Wort tại các nhà thuốc mà không cần toa.
Tuy ít gây ra tác dụng phụ nhưng những sản phẩm này lại không phát huy hiệu quả đáng kể đối với các ca trầm cảm nặng. Hơn nữa, chúng cũng có thể dẫn đến hiện tượng tương tác thuốc nếu được dùng chung một số loại thuốc khác. Do đó, để đảm bảo an toàn sức khỏe, bạn cần tham khảo ý kiến bác sĩ chuyên khoa trước khi sử dụng.
- Thực phẩm bổ sung men vi sinh psychobiotic
Trong 10 năm qua, giới chuyên môn đặc biệt quan tâm đến lợi ích của những loại vi khuẩn tốt cho sức khỏe tinh thần sống trong đường ruột.
Các nhà nghiên cứu phát hiện ra rằng, hệ khuẩn chí đường ruột của các bệnh nhân trầm cảm khác biệt rất lớn so với hệ khuẩn chí đường ruột của những người bình thường, cụ thể là sự thiếu hụt một số chủng lợi khuẩn như Lactobacillus và Bifidobacterium.
Điều này dẫn đến sự sai lệch trong quá trình dẫn truyền thông tin từ đường ruột lên bộ não, từ đó sinh ra các triệu chứng căng thẳng, lo lắng, chán nản, suy giảm nhận thức của căn bệnh trầm cảm ở người cao tuổi.
Để tái lập trạng thái cân bằng hệ vi sinh vật ở đường tiêu hóa, bảo vệ đường ruột cũng như bình thường hóa tương tác thông tin giữa đường ruột và bộ não, các nhà nghiên cứu đã cho người bệnh bổ sung một loại lợi khuẩn đặc biệt mang tên psychobiotic.
Theo các chuyên gia, probiotic (men vi sinh) giúp cải thiện rối loạn tiêu hóa (chẳng hạn tình trạng táo bón, tiêu chảy) bằng cách ảnh hưởng đến lòng ruột. Trong khi đó, psychobiotic là chủng vi lợi khuẩn có thể tác động chọn lọc lên hàng rào biểu mô ruột non (“cánh cổng” quan trọng dẫn đến niêm mạc đường ruột).
Khi xâm nhập vào hàng rào biểu mô ruột non, vi khuẩn và hóa chất độc hại sẽ tìm cách xâm nhập vào máu, kích hoạt phản ứng viêm nhiễm, làm sai lệch thông tin dẫn truyền lên não bộ, từ đó hình thành triệu chứng căng thẳng, lo âu.
Nhiều nghiên cứu đã chứng minh rằng, việc sử dụng các chủng probiotic khác nhau (trong đó có psychobiotic) đúng cách giúp cải thiện các biểu hiện trầm cảm ở mức độ nhẹ và vừa một cách rõ rệt.
Tuy nhiên, trong quá trình sử dụng, bệnh nhân cần lựa chọn đúng loại men vi sinh psychobiotic, tránh nhầm lẫn với những loại men vi sinh điều trị các vấn đề về đường tiêu hóa. Trong phần bảng thành phần, công dụng và hướng dẫn sử dụng, sản phẩm cần ghi rõ chứa psychobiotic và được chỉ định hỗ trợ kiểm soát chứng căng thẳng, mệt mỏi mạn tính, trầm cảm, rối loạn lo âu.
Một số lưu ý khi chữa bệnh trầm cảm ở người già
Trong quá trình điều trị bệnh lý, bệnh nhân cần ghi nhớ một số nguyên tắc sau:
- Chia sẻ cởi mở và chủ động tìm kiếm sự hỗ trợ từ những người xung quanh khi phát hiện các vấn đề về tâm lý, tâm thần
- Tích cực rèn luyện sức khỏe, vận động ngoài trời, tham gia nhiều bộ môn thể thao đa dạng (đi bộ, bơi lội, tập yoga, ngồi thiền, chạy bộ…)
- Duy trì sở thích cá nhân và bắt đầu những thú vui mới mẻ
- Giữ liên lạc với bạn bè, gia đình
- Tham gia câu lạc bộ văn hóa – thể thao, câu lạc bộ người già
- Thường xuyên đọc sách báo
- Ăn uống khoa học, cân bằng, đầy đủ dưỡng chất, tuyệt đối không bỏ bữa
- Tránh xa những sự kiện, vấn đề gắn liền với sự lo âu, căng thẳng, mệt mỏi
- Thưởng thức trà hoa cúc, trà hoa nhài, trà nữ lang, trà oải hương, trà bạc hà chanh, trà hoa chanh dây, trà hoa mộc lan, trà hoa đậu biếc… để xoa dịu tinh thần và dễ dàng đi vào giấc ngủ
- Thay vì lẩm bẩm nói chuyện với bản thân, hãy chọn cách trò chuyện với những người thân thương
- Bệnh trầm cảm ở người cao tuổi có thể chữa khỏi hoàn toàn, do đó, độc giả đừng quá hoang mang, lo lắng
- Kiêng cữ thuốc lá, rượu bia, cà phê và các chất kích thích
- Uống thuốc chống trầm cảm theo đúng chỉ định của bác sĩ tâm thần
- Chỉ bổ sung thực phẩm chức năng sau khi đã tham khảo ý kiến chuyên gia
- Yêu thương, trân trọng, bao dung và vị tha với bản thân, ngừng chỉ trích, phê phán và đổ lỗi cho chính mình
- Kiên trì theo đuổi liệu trình điều trị, không nản lòng bỏ cuộc giữa chừng
Gia đình đóng vai trò vô cùng quan trọng trong quá trình điều trị bệnh trầm cảm ở người già. Vì vậy, những người thân thương hãy cố gắng đồng hành xuyên suốt với bệnh nhân trong hành trình khó khăn này, đừng bao giờ để họ cảm thấy bơ vơ, lạc lõng. Tình yêu thương chân thành, sự quan tâm, chăm sóc và tấm lòng thấu hiểu có thể giúp họ vững vàng chiến thắng những cảm xúc tiêu cực, bi quan, từ đó tìm lại ý nghĩa cuộc sống và trở nên minh mẫn, khỏe mạnh.
Có thể bạn quan tâm
- Trầm cảm kháng trị là gì? Nguyên nhân và dấu hiệu nhận biết
- Trầm cảm ở trẻ vị thành niên: Dấu hiệu nhận biết và phòng tránh
- Trầm cảm trước và sau kết hôn: Nguyên nhân và cách xử lý
- Cẩn trọng với chứng trầm cảm sau khi chia tay và cách vượt qua
Trở thành người đầu tiên bình luận cho bài viết này!